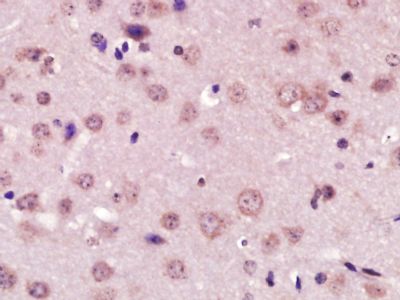
产品细节图片2

相关产品推荐更多 >
万千商家帮你免费找货
0 人在求购买到急需产品
- 详细信息
- 文献和实验
- 技术资料
- 供应商:
上海联迈生物工程有限公司
- 库存:
大量
- 目录编号:
LM-6634R
- 克隆性:
多克隆
- 抗原来源:
Rabbit
- 保质期:
1年
- 抗体英文名:
XPC
- 抗体名:
DNA补充修复XPC细胞蛋白抗体
- 宿主:
Rabbit
- 适应物种:
Human, Mouse, Rat, Dog, Pig, Cow, Horse, Guinea Pig,
- 免疫原:
KLH conjugated synthetic peptide derived from human Xeroderma pigmentosum group C:841-940/940
- 亚型:
IgG
- 形态:
Lyophilized or Liquid
- 应用范围:
ELISA=1:500-1000 IHC-P=1:400-800 IHC-F=1:400-800 IF=1:100-500 (石蜡切片需做抗原修复)
- 浓度:
1mg/ml
- 保存条件:
Store at -20 °C
- 规格:
100ul 200ul
| 英文名称 | XPC |
| 中文名称 | DNA补充修复XPC细胞蛋白抗体 |
| 别 名 | Xeroderma pigmentosum complementation group C; DNA repair protein complementing XP C cells; DNA repair protein complementing XP-C cells; DNA repair protein complementing XPC cells; p125; RAD4; Xeroderma pigmentosum group C complementing protein; Xeroderma pigmentosum group C protein; Xeroderma pigmentosum group C-complementing protein; Xeroderma pigmentosum group III; XP 3; XP C; XP group C; XP3; Xpc; XPC gene; XPC_HUMAN; XPCC. |
 |
Specific References (1) | bs-6634R has been referenced in 1 publications. [IF=8.65] Biswas, Anup Kumar, David L. Mitchell, and David G. Johnson. "E2F1 Responds to Ultraviolet Radiation by Directly Stimulating DNA Repair and Suppressing Carcinogenesis." Cancer Research (2014): canres-3216. other ; Mouse. PubMed:24741006 |
| 规格价格 | 100ul/1380元 购买 200ul/2200元 购买 大包装/询价 |
| 说 明 书 | 100ul 200ul |
| 研究领域 | 细胞生物 表观遗传学 |
| 抗体来源 | Rabbit |
| 克隆类型 | Polyclonal |
| 交叉反应 | Human, Mouse, Rat, Dog, Pig, Cow, Horse, Guinea Pig, |
| 产品应用 | ELISA=1:500-1000 IHC-P=1:400-800 IHC-F=1:400-800 IF=1:100-500 (石蜡切片需做抗原修复) not yet tested in other applications. optimal dilutions/concentrations should be determined by the end user. |
| 分 子 量 | 106kDa |
| 细胞定位 | 细胞核 细胞浆 |
| 性 状 | Lyophilized or Liquid |
| 浓 度 | 1mg/ml |
| 免 疫 原 | KLH conjugated synthetic peptide derived from human Xeroderma pigmentosum group C:841-940/940 |
| 亚 型 | IgG |
| 纯化方法 | affinity purified by Protein A |
| 储 存 液 | 0.01M TBS(pH7.4) with 1% BSA, 0.03% Proclin300 and 50% Glycerol. |
| 保存条件 | Store at -20 °C for one year. Avoid repeated freeze/thaw cycles. The lyophilized antibody is stable at room temperature for at least one month and for greater than a year when kept at -20°C. When reconstituted in sterile pH 7.4 0.01M PBS or diluent of antibody the antibody is stable for at least two weeks at 2-4 °C. |
| PubMed | PubMed |
| 产品介绍 | background: The XPC complex is proposed to represent the first factor bound at the sites of DNA damage and together with other core recognition factors, XPA, RPA and the TFIIH complex, is part of the pre-incision (or initial recognition) complex. The XPC complex recognizes a wide spectrum of damaged DNA characterized by distortions of the DNA helix such as single-stranded loops, mismatched bubbles or single stranded overhangs. The orientation of XPC complex binding appears to be crucial for inducing a productive NER. XPC complex is proposed to recognize and to interact with unpaired bases on the undamaged DNA strand which is followed by recruitment of the TFIIH complex and subsequent scanning for lesions in the opposite strand in a 5'-to-3' direction by the NER machinery. Cyclobutane pyrimidine dimers (CPDs) which are formed upon UV-induced DNA damage esacpe detection by the XPC complex due to a low degree of structural perurbation. Instead they are detected by the UV-DDB complex which in turn recruits and cooperates with the XPC complex in the respective DNA repair. In vitro, the XPC:RAD23B dimer is sufficient to initiate NER; it preferentially binds to cisplatin and UV-damaged double-stranded DNA and also binds to a variety of chemically and structurally diverse DNA adducts. XPC:RAD23B contacts DNA both 5' and 3' of a cisplatin lesion with a preference for the 5' side. XPC:RAD23B induces a bend in DNA upon binding. XPC:RAD23B stimulates the activity of DNA glycosylases TDG and SMUG1. Function: Involved in global genome nucleotide excision repair (GG-NER) by acting as damage sensing and DNA-binding factor component of the XPC complex. Has only a low DNA repair activity by itself which is stimulated by RAD23B and RAD23A. Has a preference to bind DNA containing a short single-stranded segment but not to damaged oligonucleotides. This feature is proposed to be related to a dynamic sensor function: XPC can rapidly screen duplex DNA for non-hydrogen-bonded bases by forming a transient nucleoprotein intermediate complex which matures into a stable recognition complex through an intrinsic single-stranded DNA-binding activity. The XPC complex is proposed to represent the first factor bound at the sites of DNA damage and together with other core recognition factors, XPA, RPA and the TFIIH complex, is part of the pre-incision (or initial recognition) complex. The XPC complex recognizes a wide spectrum of damaged DNA characterized by distortions of the DNA helix such as single-stranded loops, mismatched bubbles or single stranded overhangs. The orientation of XPC complex binding appears to be crucial for inducing a productive NER. XPC complex is proposed to recognize and to interact with unpaired bases on the undamaged DNA strand which is followed by recruitment of the TFIIH complex and subsequent scanning for lesions in the opposite strand in a 5'-to-3' direction by the NER machinery. Cyclobutane pyrimidine dimers (CPDs) which are formed upon UV-induced DNA damage esacpe detection by the XPC complex due to a low degree of structural perurbation. Instead they are detected by the UV-DDB complex which in turn recruits and cooperates with the XPC complex in the respective DNA repair. In vitro, the XPC:RAD23B dimer is sufficient to initiate NER; it preferentially binds to cisplatin and UV-damaged double-stranded DNA and also binds to a variety of chemically and structurally diverse DNA adducts. XPC:RAD23B contacts DNA both 5' and 3' of a cisplatin lesion with a preference for the 5' side. XPC:RAD23B induces a bend in DNA upon binding. XPC:RAD23B stimulates the activity of DNA glycosylases TDG and SMUG1. Subunit: Component of the XPC complex composed of XPC, RAD23B and CETN2. Interacts with RAD23A; the interaction is suggesting the existence of a functional equivalent variant XPC complex. Interacts with TDG; the interaction is demonstrated using the XPC:RAD23B dimer. Interacts with SMUG1; the interaction is demonstrated using the XPC:RAD23B dimer. Interacts with DDB2. Interacts with CCNH, GTF2H1 and ERCC3. Subcellular Location: Nucleus. Cytoplasm. Note=Omnipresent in the nucleus and consistently associates with and dissociates from DNA in the absence of DNA damage. Continuously shuttles between the cytoplasm and the nucleus, which is impeded by the presence of NER lesions. DISEASE: Defects in XPC are a cause of xeroderma pigmentosum complementation group C (XP-C) [MIM:278720]; also known as xeroderma pigmentosum III (XP3). XP-C is a rare human autosomal recessive disease characterized by solar sensitivity, high predisposition for developing cancers on areas exposed to sunlight and, in some cases, neurological abnormalities. Similarity: Belongs to the XPC family. SWISS: Q01831 Gene ID: 7508 Database links: Entrez Gene: 7508 Human Entrez Gene: 22591 Mouse Entrez Gene: 312560 Rat Omim: 613208 Human SwissProt: Q01831 Human SwissProt: P51612 Mouse Unigene: 475538 Human Unigene: 2806 Mouse Unigene: 22820 Rat Important Note: This product as supplied is intended for research use only, not for use in human, therapeutic or diagnostic applications. |
| 产品图片 | Paraformaldehyde-fixed, paraffin embedded (Mouse brain); Antigen retrieval by boiling in sodium citrate buffer (pH6.0) for 15min; Block endogenous peroxidase by 3% hydrogen peroxide for 20 minutes; Blocking buffer (normal goat serum) at 37°C for 30min; Antibody incubation with (XPC) Polyclonal Antibody, Unconjugated (bs-6634R) at 1:400 overnight at 4°C, followed by operating according to SP Kit(Rabbit) (sp-0023) instructionsand DAB staining.  Paraformaldehyde-fixed, paraffin embedded (rat brain); Antigen retrieval by boiling in sodium citrate buffer (pH6.0) for 15min; Block endogenous peroxidase by 3% hydrogen peroxide for 20 minutes; Blocking buffer (normal goat serum) at 37°C for 30min; Antibody incubation with (XPC) Polyclonal Antibody, Unconjugated (bs-6634R) at 1:200 overnight at 4°C, followed by a conjugated secondary (sp-0023) for 20 minutes and DAB staining.  Tissue/cell: human gastric cancer; 4% Paraformaldehyde-fixed and paraffin-embedded; Antigen retrieval: citrate buffer ( 0.01M, pH 6.0 ), Boiling bathing for 15min; Block endogenous peroxidase by 3% Hydrogen peroxide for 30min; Blocking buffer (normal goat serum,C-0005) at 37℃ for 20 min; Incubation: Anti-XPC Polyclonal Antibody, Unconjugated(bs-6634R) 1:200, overnight at 4°C, followed by conjugation to the secondary antibody(SP-0023) and DAB(C-0010) staining  Paraformaldehyde-fixed, paraffin embedded (rat brain); Antigen retrieval by boiling in sodium citrate buffer (pH6) for 15min; Block endogenous peroxidase by 3% hydrogen peroxide for 20 minutes; Blocking buffer (normal goat serum) at 37°C for 30min; Antibody incubation with (XPC) Polyclonal Antibody, Unconjugated (bs-6634R) at 1:200 overnight at 4°C, followed by a conjugated secondary (bs-0295G-Cy3) at [1:500] for 90 minutes and DAPI staining of the nuclei. |
风险提示:丁香通仅作为第三方平台,为商家信息发布提供平台空间。用户咨询产品时请注意保护个人信息及财产安全,合理判断,谨慎选购商品,商家和用户对交易行为负责。对于医疗器械类产品,请先查证核实企业经营资质和医疗器械产品注册证情况。
 文献和实验
文献和实验利用荧光显微镜可以对单个枯草杆菌细胞内DNA的修复组装和 DNA复制复合物进行成像,特别是可以成像错配修复蛋白,SOS诱导蛋白及同源重组、DNA复制状态。0:00 枯草杆菌DNA损伤的错配修复和细胞应激影像 0:21 内容订阅 0:45 内容简介 1:18 培养用于显微镜观察的细胞 4:55 准备用于成像的细胞 7:58 观察细胞 9:11 代表性枯草杆菌DNA损伤时的应激反应影像 10:05 结论 枯草杆菌DNA损伤的错配修复和细胞应激影像本视频来源于网络,如有异议请联系
GENETICS:用于检测哺乳动物细胞中 DNA-蛋白质交联质粒修复的简单、快速的定量分析
该方法的目的是提供灵活,快速和定量的技术来检测哺乳动物细胞系中DNA-蛋白质交联(DPC)修复的动力学。该测定不是全局测定异种生物诱导的或自发的染色体DPC去除的去除,而是检查在质粒DNA底物内的一个位点处特异性引入的均匀的,化学定义的损伤的修复。这种方法避免了放射性物质的使用,并且不依赖昂贵的或高度专业化的技术。相反,它依赖于标准的重组DNA程序和广泛可用的实时定量聚合酶链式反应(qPCR)仪器。考虑到所用策略的固有灵活性,可以改变交联蛋白的大小以及化学连接的性质和连接位点的精确 DNA
Cancer Cell:詹启敏院士团队合作研究揭示肠道微生物影响直肠癌新辅助治疗疗效的原因
生物合成,能降低肿瘤细胞的生存,而外源性核苷的补充能够抵消化疗药物对嘧啶或嘌呤从头生物合成的抑制,使得降低肿瘤细胞 DNA 双链损伤从而存活。进一步利用核苷转运蛋白的抑制剂阻断外源性核苷摄取能够减弱核苷混合物对 5-氟尿嘧啶或电离辐射的保护作用,抑制电离辐射后 DNA 双链损伤的修复,证实了外源性核苷补充能够帮助肿瘤细胞从肿瘤治疗的打击中存活下来。 图片来源:Cancer Cell 4. 体内实验揭示 B. vulgatus 介导的核苷酸生物合成有助原位结直肠肿瘤抵抗治疗 体内动物实验证明核苷的补充
 技术资料
技术资料暂无技术资料 索取技术资料










